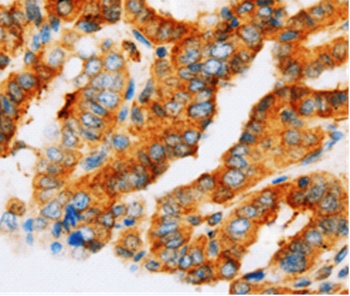

gamma Adaptin Antibody (YA2993)
HY-P83248
TargetAP1G1
Product group Antibodies
Overview
- SupplierMedChem Express
- Product Namegamma Adaptin Antibody (YA2993)
- Delivery Days Customer5
- CertificationResearch Use Only
- ClonalityMonoclonal
- Gene ID164
- Target nameAP1G1
- Target descriptionadaptor related protein complex 1 subunit gamma 1
- Target synonymsadapter-related protein complex 1 subunit gamma-1; adaptor protein complex AP-1 subunit gamma-1; adaptor related protein complex 1 gamma 1 subunit; ADTG; AP-1 complex subunit gamma-1; CLAPG1; clathrin assembly protein complex 1 gamma large chain; clathrin assembly protein complex 1 gamma-1 large chain; clathrin-associated/assembly/adaptor protein, large, gamma 1; gamma adaptin; gamma1-adaptin; golgi adaptor HA1/AP1 adaptin gamma subunit; golgi adaptor HA1/AP1 adaptin subunit gamma-1; testicular tissue protein Li 21
- HostRabbit
- IsotypeIgG
- Scientific Descriptiongamma Adaptin Antibody (YA2993) is a rabbit-derived non-conjugated IgG antibody (Clone NO.: YA2993), targeting gamma Adaptin, with a predicted molecular weight of 91 kDa (observed band size: 100 kDa). gamma Adaptin Antibody (YA2993) can be used for WB, IHC-P experiment in human, mouse, rat background.
- Storage Instruction-20°C
- UNSPSC12352203